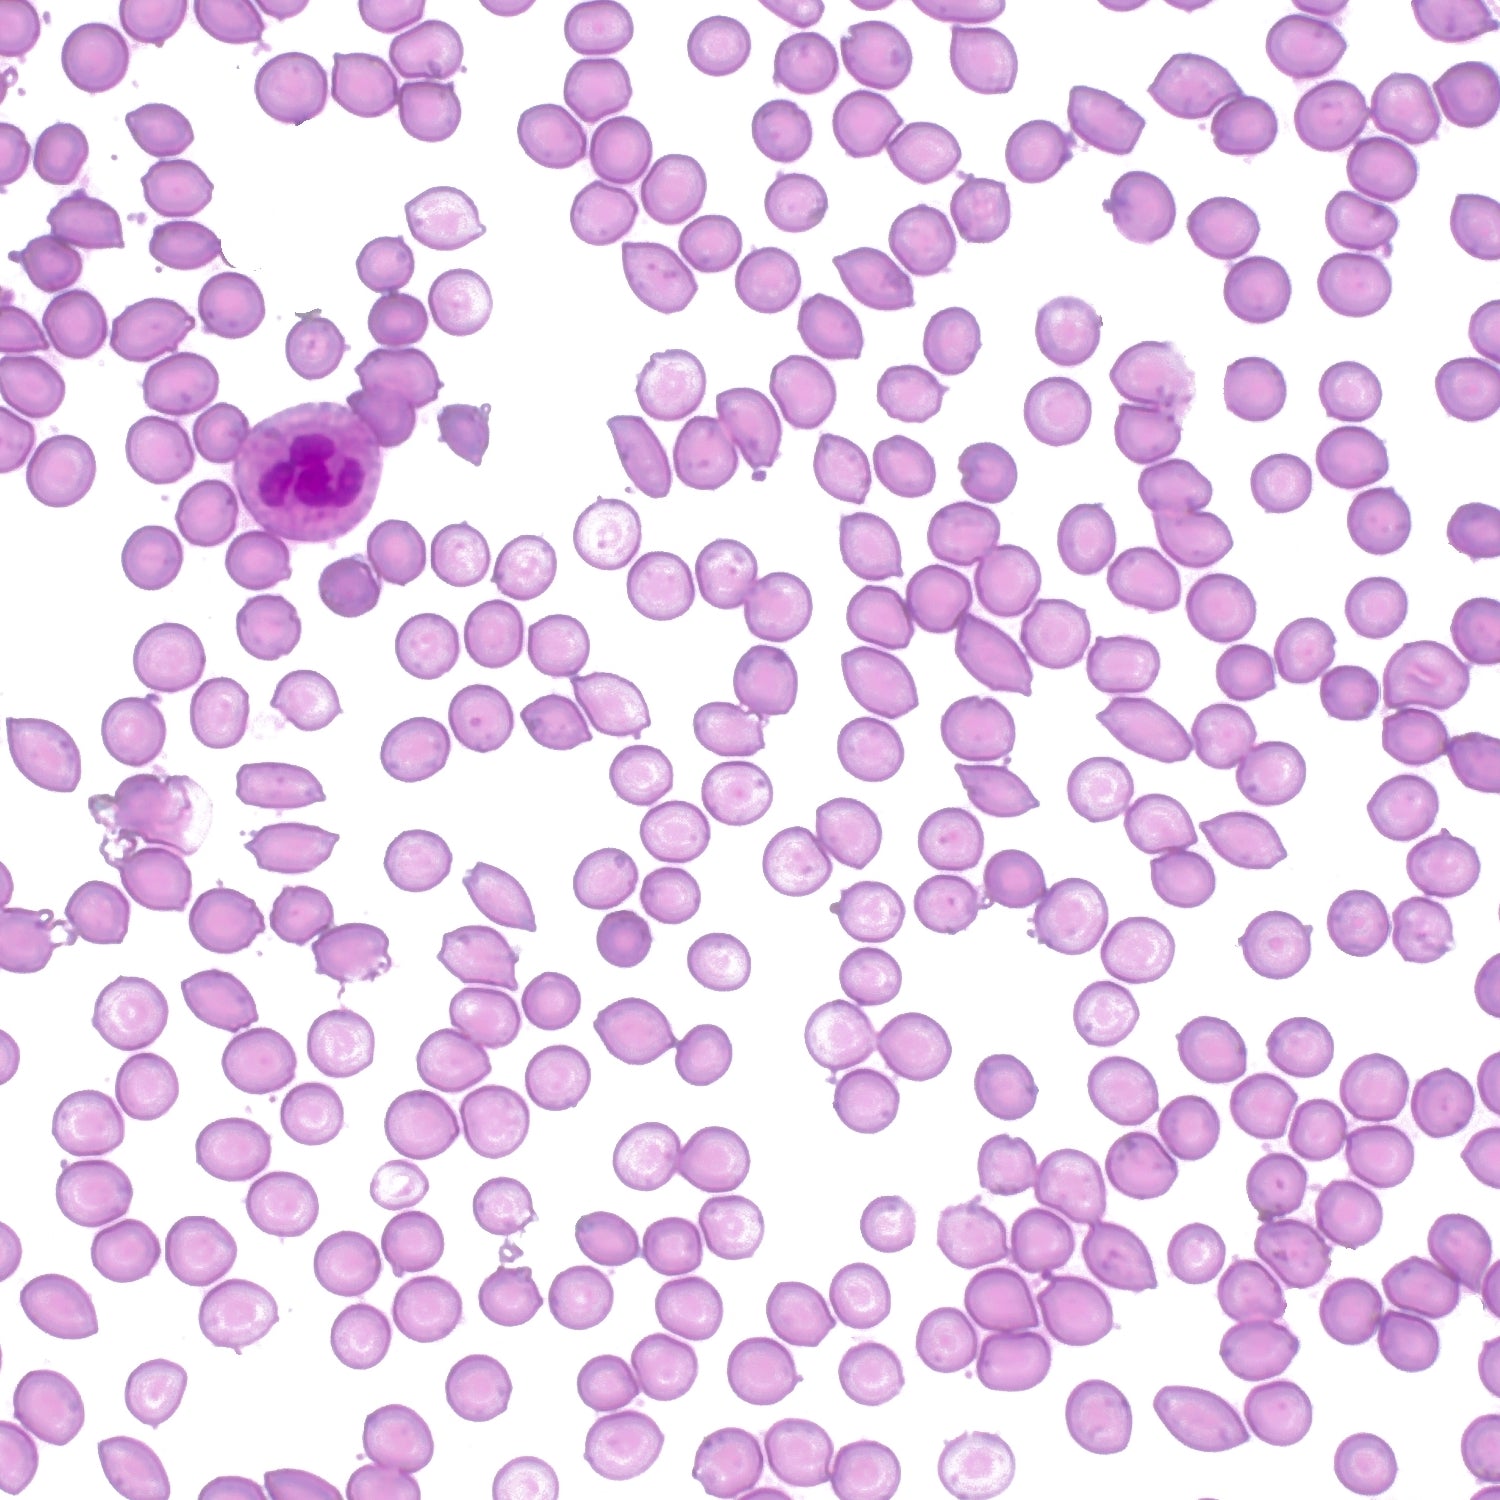

What is HOCL?
HOCL is the natural ingredient our body produces to disinfect and keep us healthy.
Facts of HOCL
Our not-so-secret ingredient goes back a long, long way—to the very beginning of humanity.
HOCL or Hypochlorous Acid is made by the human body. Our white blood cells produce it, then they send it out on missions when you’re sick or you have an infection to kill the germs, viruses, and other bad things invading your body.

That means HOCL was inside of your Neanderthal ancestors, just like it’s inside of you right now.

In our Southern California Lab, we mix up a carefully measured solution of salt and water. Then we electro-activate it—delivering a bolt of electricity that creates Hypochlorous Acid.
We package up the water, salt, and Hypochlorous Acid together to make our powerful products.
The Secret is Out!

For years, the HOCL has been used to disinfect hospitals and clean wounds because it’s so safe and so effective.
It eliminates 99.9% of germs. And it kills all of the bad stuff and none of the good stuff.

HOCl can prevent virus and bacteria growth without affecting lung and skin tissues, making this compound a perfect candidate to sanitize indoor environments.

Medical professionals know that HOCL is naturally present in all protecting and healing mammals; that includes close to 8 billion humans. HOCL defends against all manner of pathogens and potential pathogens that attack the body from both outside and inside.

The reason the HOCL was only used in hospitals before was a packaging problem. No one had found a way to keep it stable on shelf to sell it in stores.
We’ve solved that problem, and we’ve done one better. We know that the easiest way to use HOCL is to spray it—so we created a special environmentally-friendly spray for a super convenient experience.
Our SPR-AIR Technology™ is non-flammable, non-VOC, and non-greenhouse gas.
You win. The earth wins. And the only ones who lose are the germs.

